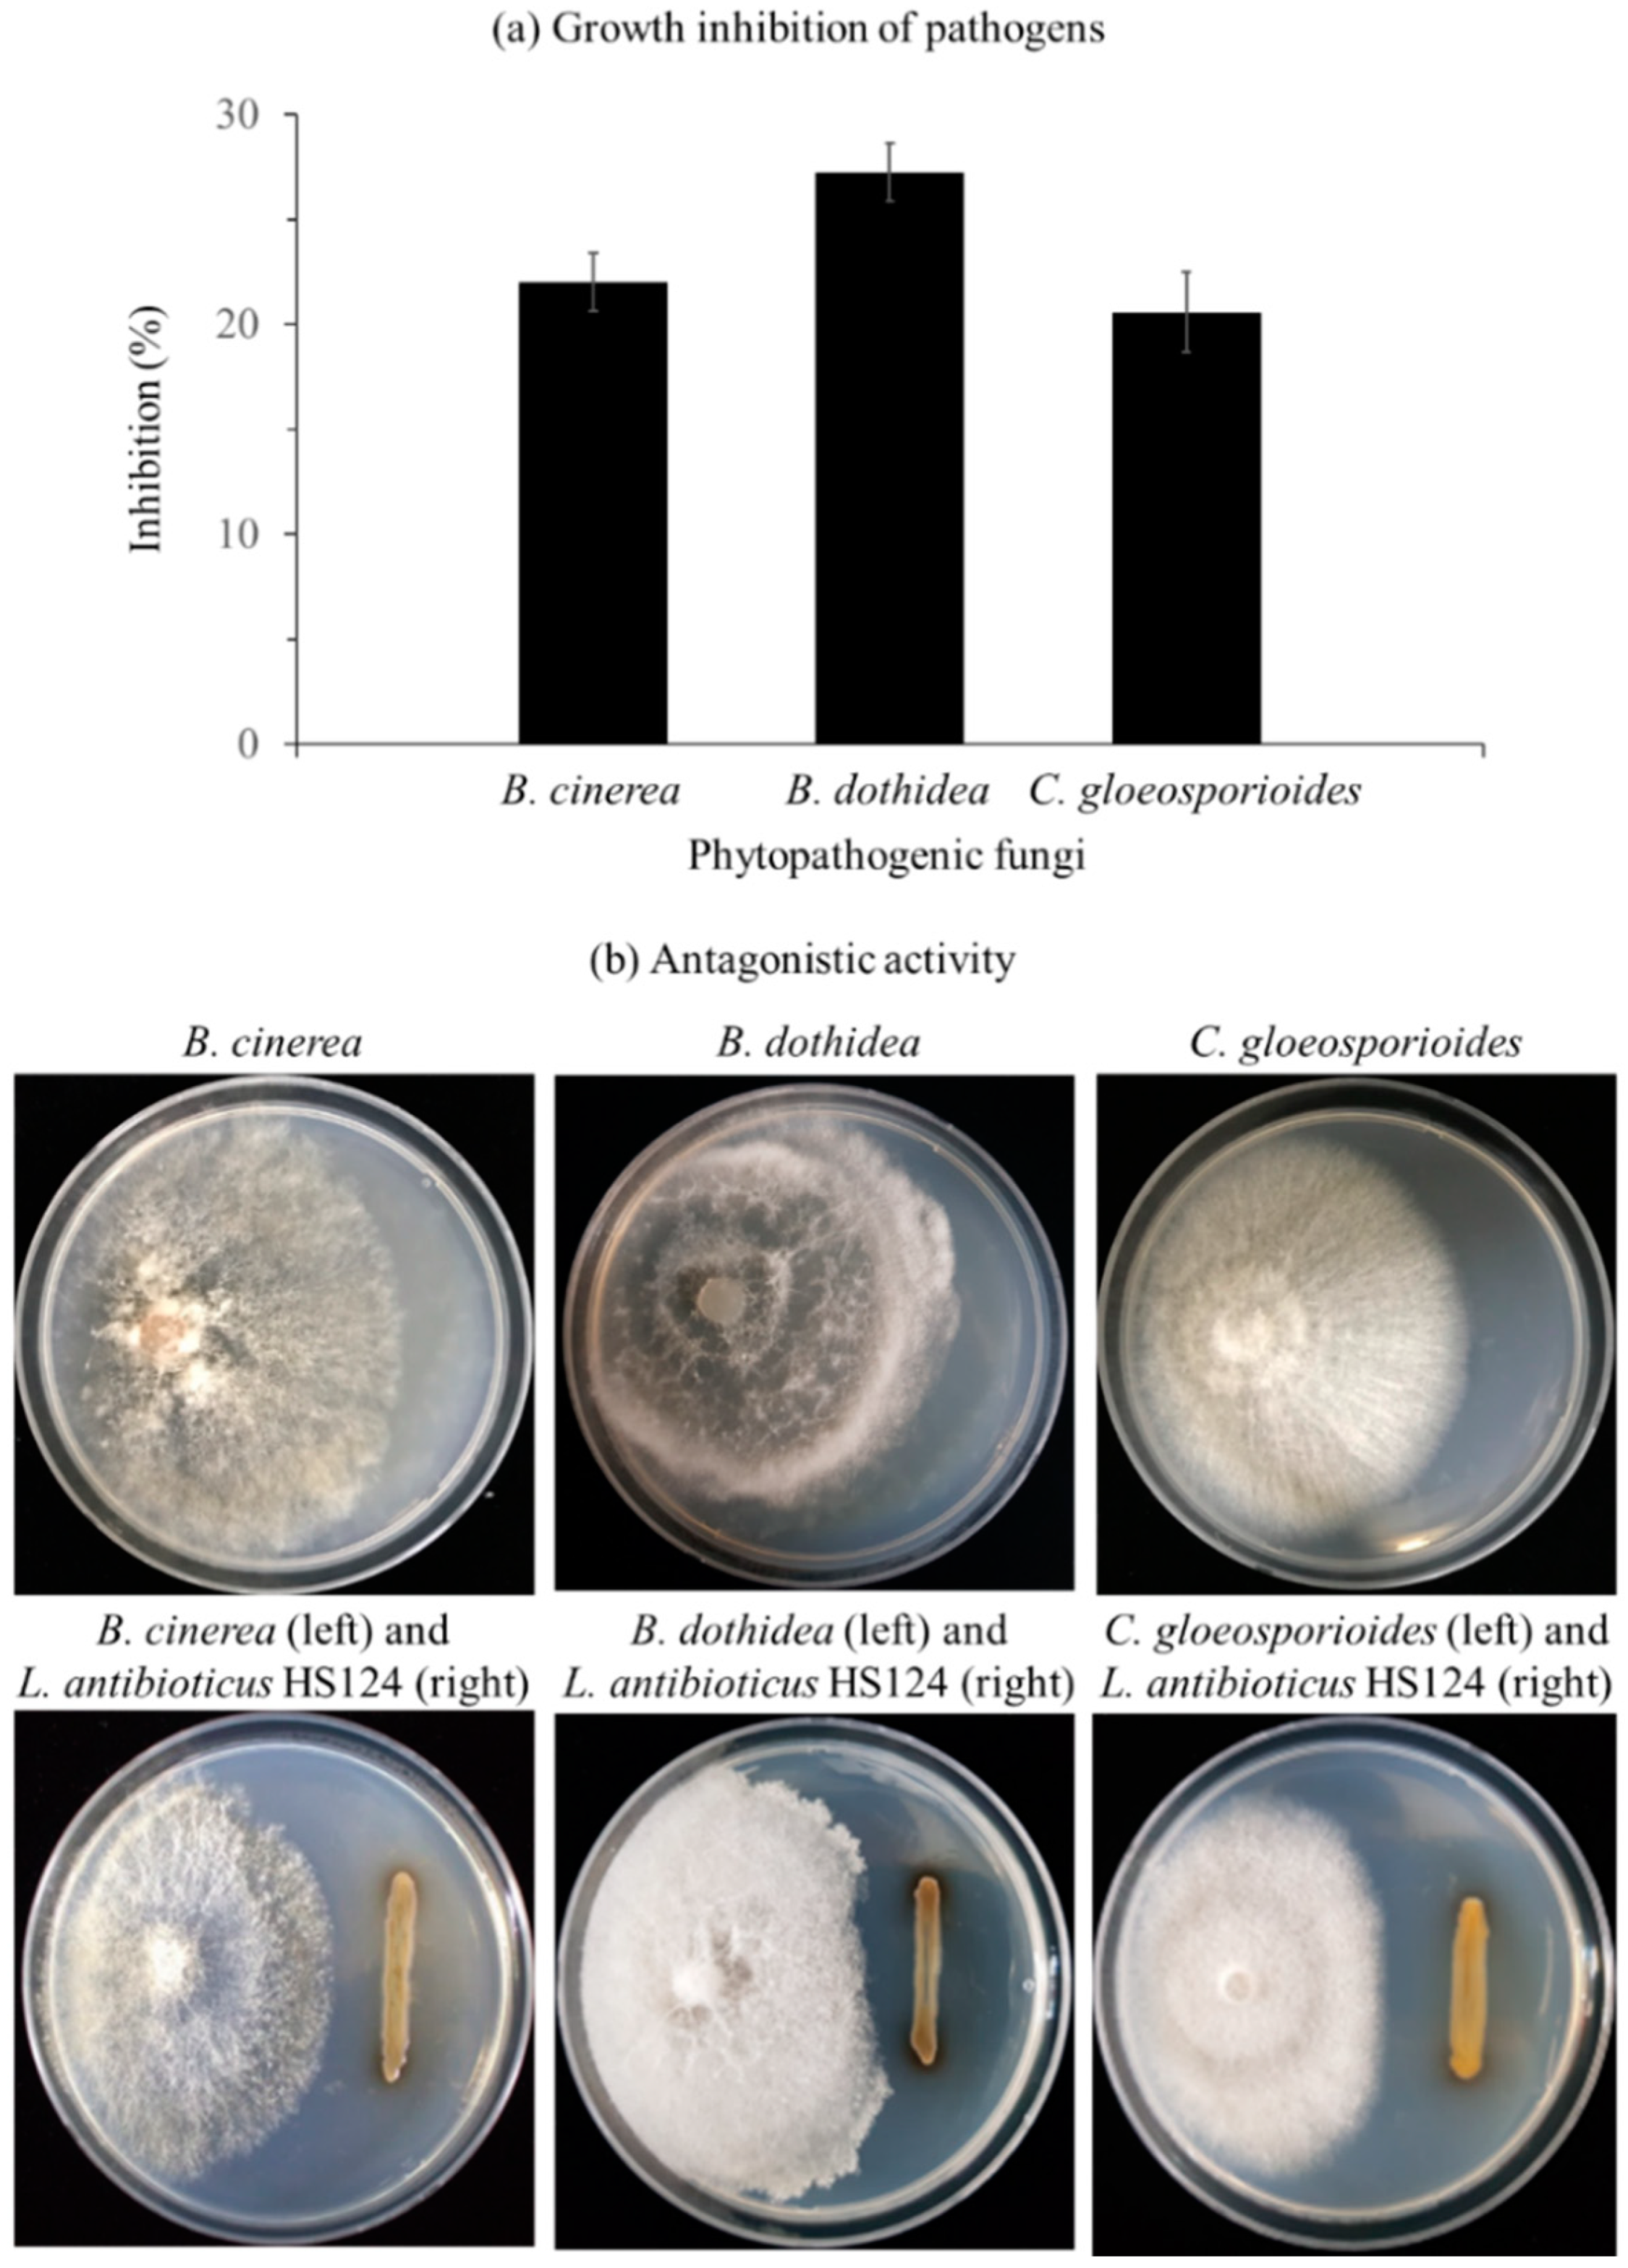
Forests 10 01146 g004 Forests 10 01146 g004

Control of Fungal Diseases and Increase in Yields of a Cultivated Jujube Fruit (Zizyphus jujuba Miller var. inermis Rehder) Orchard by Employing Lysobacter antibioticus HS124
Abstract
1. Introduction
2. Materials and Methods
2.1. Bacterial Culture
2.2. Chitinase Activity
2.3. Antifungal Activity of L. antibioticus HS124 toward Fungal Phytopathogens
2.4. Indole-3-Acetic Acid (IAA) Production by L. antibioticus HS124
2.5. Study Area and Field Experimental Conditions
2.6. Mineral Concentration, Fruit Characteristics, and Yield
2.7. Statistical Analysis
3. Results
3.1. Inhibitory Effect of L. antibioticus HS124 on Growth of Fungal Pathogens
3.1.1. Chitinase Activity
3.1.2. Growth Inhibition of Phytopathogenic Fungi by L. antibioticus HS124
3.2. Effect of L. antibioticus HS124 on Fruit Yield
3.2.1. IAA Production
3.2.2. Mineral Concentration, Characteristics, and Yield of Jujube Fruits
4. Discussion
5. Conclusions
Author Contributions
Funding
Acknowledgments
Conflicts of Interest
References
- Pareek, S. Nutritional composition of jujube fruit. Emir. J. Food Agric. 2013, 25, 463–470. [Google Scholar] [CrossRef]
- Liu, M.J.; Cheng, C.Y. A taxonomic study on the genus Ziziphus. Acta Hortic. 1995, 390, 161–165. [Google Scholar] [CrossRef]
- Hernández, F.; Legua, P.; Melgarejo, P.; Martinez, R.; Martinez, J.J. Phenological growth stages of jujube tree (Ziziphus jujube): Codification and description according to the BBCH scale. Ann. Appl. Biol. 2015, 166, 136–142. [Google Scholar] [CrossRef]
- Krša, B.; Mishra, S. Sensory evaluation of different products of Ziziphus jujuba Mill. Acta Hortic. 2009, 840, 557–562. [Google Scholar] [CrossRef]
- Gao, Q.H.; Wu, C.S.; Wang, M.; Xu, B.N.; Du, L.J. Effect of drying of jujubes (Ziziphus jujuba Mill.) on the contents of sugars, organic acids, α-tocopherol, β-carotene, and phenolic compounds. J. Agric. Food Chem. 2012, 60, 9642–9648. [Google Scholar] [CrossRef]
- Wojdyło, A.; Ángel, A.C.B.; Legua, P.; Hernández, F. Phenolic composition, ascorbic acid content, and antioxidant capacity of Spanish jujube (Ziziphus jujube Mill.) fruit. Food Chem. 2016, 201, 307–314. [Google Scholar] [CrossRef]
- Shahrajabian, M.H.; Khoshkharam, M.; Zandi, P.; Sun, W.; Cheng, Q. Jujube, a super-fruit in traditional Chinese medicine, heading for modern pharmacological science. J. Med. Plants Stud. 2019, 7, 173–178. [Google Scholar]
- Godbole, S. Overview of traditional knowledge and scientific research on medicinal uses of leaves and flowers offered during festivals. World J. Pharmaceut. Res. 2018, 7, 523–546. [Google Scholar] [CrossRef]
- Goyal, M.; Nagori, B.P.; Sasmal, D. Review on ethnomedicinal uses, pharmacological activity and phytochemical constituents of Ziziphus mauritiana (Z. jujube Lam., non Mill). Spatula DD 2012, 2, 107–116. [Google Scholar] [CrossRef]
- Marrelli, M.; Conforti, F.; Araniti, F.; Statti, G.A. Effects of saponins on lipid metabolism: A review of potential health benefits in the treatment of obesity. Molecules 2016, 21, 1404. [Google Scholar] [CrossRef]
- Hernández, F.; Luis, N.A.; Burló, F.; Wojdyło, A.; Ángel, A.C.B.; Legua, P. Physico-chemical, nutritional, and volatile composition and sensory profile of Spanish jujube (Ziziphus jujube Mill.) fruits. J. Sci. Food Agric. 2016, 96, 2682–2691. [Google Scholar] [CrossRef] [PubMed]
- Guo, S.; Duan, J.A.; Tang, Y.; Su, S.; Shang, E.; Ni, S.; Qian, D. High-performance liquid chromatography–wo wavelength detection of triterpenoid acids from the fruits of Ziziphus jujuba containing various cultivars in different regions and classification using chemometric analysis. J. Pharmaceut. Biomed. 2009, 49, 1296–1302. [Google Scholar] [CrossRef] [PubMed]
- Zhang, H.; Jiang, L.; Ye, S.; Ye, Y.; Ren, F. Systematic evaluation of antioxidant capacities of the ethanolic extract of different tissues of jujube (Ziziphus jujube Mill.) from China. Food Chem. Toxicol. 2010, 48, 1461–1465. [Google Scholar] [CrossRef] [PubMed]
- Morton, J.F. Fruits of Warm Climates; Purdue University: Miami, FL, USA, 1987; pp. 272–275. [Google Scholar]
- Williamson, B.; Tudzynski, B.; Tudzynski, P.; Kan, J.A.L.V. Botrytis cinerea: The cause of grey mould disease. Mol. Plant Pathol. 2007, 8, 561–580. [Google Scholar] [CrossRef] [PubMed]
- Phoulivong, S.; Cai, L.; Chen, H.; McKenzie, E.H.C.; Abdelsalam, K.; Chukeatirote, E.; Hyde, K.D. Colletotrichum gloeosporioides is not a common pathogen on tropical fruits. Fungal Divers. 2010, 44, 33–43. [Google Scholar] [CrossRef]
- Zhu, H.Y.; Tian, C.M.; Fan, X.L. Studies of botryosphaerialean fungi associated with canker and dieback of tree hosts in Dongling Mountain of China. Phytotaxa 2018, 348, 63–76. [Google Scholar] [CrossRef]
- He, C.; Zhang, Z.; Li, B.; Xu, Y.; Tian, S. Effect of natamycin on Botrytis cinerea and Penicillium expansum−Postharvest pathogens of grape berries and jujube fruit. Postharvest Biol. Technol. 2019, 151, 134–141. [Google Scholar] [CrossRef]
- O’connell, P.F. Sustainable agriculture—A valid alternative. Outlook Agric. 1992, 21, 5–12. [Google Scholar] [CrossRef]
- Gisi, U.; Sierotzki, H.; Cook, A.; McCaffery, A. Mechanisms influencing the evolution of resistance to Qo inhibitor fungicides. Pest Manag. Sci. 2002, 58, 859–867. [Google Scholar] [CrossRef]
- Savci, S. An agricultural pollutant: Chemical fertilizer. Int. J. Environ. Sci. Dev. 2012, 3, 77–80. [Google Scholar] [CrossRef]
- Juntunen, M.L.; Hammar, T.; Rikala, R. Leaching of nitrogen and phosphorus during production of forest seedlings in containers. J. Environ. Qual. 2002, 31, 1868–1874. [Google Scholar] [CrossRef] [PubMed]
- Youssef, M.M.A.; Eissa, M.F.M. Biofertilizers and their role in management of plant parasitic nematodes. A review. E3 J. Biotechnol. Pharm. Res. 2014, 5, 1–6. [Google Scholar]
- Glick, B.R.; Penrose, D.M.; Li, J. A Model for the lowering of plant ethylene concentrations by plant growth-promoting bacteria. J. Theor. Biol. 1998, 190, 63–68. [Google Scholar] [CrossRef] [PubMed]
- Glick, B.R. Plant growth-promoting bacteria: Mechanisms and applications. Scientifica 2012, 2012, 963401. [Google Scholar] [CrossRef] [PubMed]
- Orhan, E.; Esitken, A.; Ercisli, S.; Turan, M.; Sahin, F. Effects of plant growth promoting rhizobacteria (PGPR) on yield, growth and nutrient contents in organically growing raspberry. Sci. Hortic. 2006, 111, 38–43. [Google Scholar] [CrossRef]
- Won, S.-J.; Choub, V.; Kwon, J.-H.; Kim, D.-H.; Ahn, Y.-S. The control of fusarium root rot and development of coastal pine (Pinus thunbergii Parl.) seedlings in a container nursery by use of Bacillus licheniformis MH48. Forests 2019, 10, 6. [Google Scholar] [CrossRef]
- Won, S.-J.; Kwon, J.-H.; Kim, D.-H.; Ahn, Y.-S. The effect of Bacillus licheniformis MH48 on control of foliar fungal diseases and growth promotion of Camellia oleifera seedling in the coastal reclaimed land of Korea. Patohgens 2019, 8, 6. [Google Scholar] [CrossRef]
- Glick, B.R. The enhancement of plant growth by free-living bacteria. Can. J. Microbiol. 1995, 41, 109–117. [Google Scholar] [CrossRef]
- Ko, H.-S.; Jin, R.-D.; Krishnan, H.B.; Lee, S.-B.; Kim, K.-Y. Biocontrol ability of Lysobacter antibioticus HS124 against Phytophthora blight is mediated by the production of 4-Hydroxyphenylacetic acid and several lytic enzymes. Curr. Microbiol. 2009, 59, 608–615. [Google Scholar] [CrossRef]
- Gravel, V.; Antoun, H.; Tweddell, R.J. Growth stimulation and fruit yield improvement of greenhouse tomato plants by inoculation with Pseudomonas putida or Trichoderma atroviride: Possible role of indole acetic acid (IAA). Soil Biol. Biolchem. 2007, 39, 1968–1977. [Google Scholar] [CrossRef]
- Goswami, D.; Thakker, J.N.; Dhandhukia, P.C. Portraying mechanics of plant growth promoting rhizobacteria (PGPR): A review. Cogent Food Agric. 2016, 2. [Google Scholar] [CrossRef]
- Srivastava, A.; Handa, A.K. Hormonal regulation of tomato fruit development: A molecular perspective. J. Plant Growth Regul. 2005, 24, 67–82. [Google Scholar] [CrossRef]
- Liu, D.J.; Chen, J.Y.; Lu, W.J. Expression and regulation of the early auxin-responsive Aux/IAA genes during strawberry fruit development. Mol. Biol. Rep. 2011, 38, 1187–1193. [Google Scholar] [CrossRef] [PubMed]
- Han, T.; Cho, M.-Y.; Lee, Y.-S.; Park, Y.-S.; Park, R.-D.; Nam, Y.; Kim, K.-Y. Biocontrol of pepper diseases by Lysobacter enzymogenes LE429 and Neem Oil. Korean J. Soil Sci. Fert. 2010, 43, 490–497. [Google Scholar]
- Esitken, A.; Ercisli, S.; Karlidag, H.; Sahin, F. Potential use of plant growth promoting rhizobacteria (PGPR) in organic apricot production. In Proceedings of the International Scientific Conference, Polli, Estonia, 7–9 September 2005; Libek, A., Kaufmane, E., Sasnauskas, A., Eds.; Tartu University Press: Tartu, Estonia, 2005; pp. 90–97. [Google Scholar]
- Widdel, F. Theory and measurement of bacterial growth. Grund. Mikrobiol. 2007, 4, 1–11. [Google Scholar]
- Berger, L.R.; Reynolds, D.M. The chitinase system of a strain of Streptomyces griseus. Biochim. Biophys. Acta 1958, 29, 522–534. [Google Scholar] [CrossRef]
- Kim, Y.-T.; Monkhung, S.; Lee, Y.S.; Kim, K.Y. Effects of Lysobacter antibioticus HS124, an effective biocontrol agent against Fusarium graminearum, on crown rot disease and growth promotion of wheat. Can. J. Microbiol. 2019, 65, 904–912. [Google Scholar] [CrossRef]
- Lingappa, Y.; Lockwood, J. Chitin media for selective isolation and culture of Actinomycetes. Phytopathology 1962, 52, 317–323. [Google Scholar]
- Rahman, A.; Sitepu, I.R.; Tang, S.Y.; Hashidoko, Y. Salkowski’s reagent test as a primary screening index for functionalities of rhizobacteria isolated from wild dipterocarp saplings growing naturally on medium-strongly acidic tropical peat soil. Biosci. Biotechnol. Biochem. 2010, 74, 2202–2208. [Google Scholar] [CrossRef]
- Association of Analytical Communities. Official Methods of Analysis of the Association of Official Analytical Chemists, 15th ed.; Helich, K., Ed.; Association of Official Analytical Chemists, Inc.: Arlington, VA, USA, 1990; Volume 1, pp. 40–58. [Google Scholar]
- Brzezinska, M.S.; Jankiewicz, U. Production of antifungal chitinase by Aspergillus niger LOCK 62 and its potential role in the biological control. Curr. Microbiol. 2012, 65, 666–672. [Google Scholar] [CrossRef]
- Velusamy, P.; Kim, K.Y. Chitinolytic activity of Enterobacter sp. KB3 antagonistic to Rhizoctonia solani and its role in the degradation of living fungal hyphae. Int. Res. J. Microbiol. 2011, 2, 206–214. [Google Scholar]
- Ipek, M.; Pirlak, L.; Esitken, A.; Donmez, M.F.; Turan, M.; Sahin, F. Plant growth-promoting rhizobacteria (PGPR) increase yield, growth and nutrition of strawberry under high-calcareous soil conditions. J. Plant Nutr. 2014, 37, 990–1001. [Google Scholar] [CrossRef]
- Brewster, J.L. Onions and other vegetable alliums. Sci. Hortic. 1994, 62, 145–149. [Google Scholar] [CrossRef]
- Osman, A.G.; Elaziz, F.I.A.; Elhassan, G.A. Effects of biological and mineral fertilization on yield, chemical composition and physical characteristics of faba bean (Vicia faba L.) cultivar seleim. Pak. J. Nutr. 2010, 9, 703–708. [Google Scholar] [CrossRef][Green Version]
- Rizk, F.A.; Shaheen, A.M.; Elsamad, E.H.A.; Sawan, O.M. Effect of different nitrogen plus phosphorus and Sulphur fertilizer levels on growth, yield and quality of onion (Allium cepa L.). J. Appl. Sci. Res. 2012, 8, 3353–3361. [Google Scholar]
- Raklami, A.; Bechtaoul, N.; Tahiri, A.; Anli, M.; Meddich, A.; Oufdou, K. Use of rhizobacteria and mycorrhizae consortium in the open field as a strategy for improving crop nutrition, productivity and soil fertility. Front. Microbiol. 2019, 10, 1106. [Google Scholar] [CrossRef]
- Yolcu, H.; Gunes, A.; Gullap, M.K.; Cakmakci, R. Effects of plant growth-promoting rhizobacteria on some morphologic characteristics, yield and quality contents of Hungarian vetch. Turk. J. Field Crop. 2012, 17, 208–214. [Google Scholar]
- Pirlak, L.; Turan, M.; Sahin, F.; Esitken, A. Floral and foliar application of plant growth promoting rhizobacteria (PGPR) to apples increase yield, growth, and nutrient element contents of leaves. J. Sustain. Agric. 2007, 30, 145–155. [Google Scholar] [CrossRef]
- Park, H.-G.; Lee, Y.-S.; Kim, K.-Y.; Park, Y.-S.; Park, K.-H.; Han, T.-H.; Park, C.-M.; Ahn, Y.S. Inoculation with Bacillus licheniformis MH48 promotes nutrient uptake in seedling of the ornamental plant Camellia japonica grown in Korea reclaimed coastal lands. Hortic. Sci. Technol. 2017, 35, 11–20. [Google Scholar] [CrossRef]

| Treatment | Fruit Mineral (g/kg) | Fruit Characteristics (mm) | Fruit Yield (g) | ||||
|---|---|---|---|---|---|---|---|
| K | Ca | Mg | P | Length | Diameter | ||
| Control | 1.18 ± 0.18 * | 0.05 ± 0.01 * | 0.04 ± 0.01 * | 0.15 ± 0.02 * | 29.66 ± 1.67 * | 23.77 ± 1.24 * | 2165.78 ± 221.19 * |
| Bacterial inoculation | 2.12 ± 0.17 * | 0.08 ± 0.01 * | 0.08 ± 0.01 * | 0.21 ± 0.03 * | 38.37 ± 1.41 * | 28.99 ± 1.53 * | 6284.67 ± 1207.23 * |
© 2019 by the authors. Licensee MDPI, Basel, Switzerland. This article is an open access article distributed under the terms and conditions of the Creative Commons Attribution (CC BY) license (http://creativecommons.org/licenses/by/4.0/).
Share and Cite
Kwon, J.-H.; Won, S.-J.; Moon, J.-H.; Kim, C.-W.; Ahn, Y.-S. Control of Fungal Diseases and Increase in Yields of a Cultivated Jujube Fruit (Zizyphus jujuba Miller var. inermis Rehder) Orchard by Employing Lysobacter antibioticus HS124. Forests 2019, 10, 1146. https://doi.org/10.3390/f10121146
Kwon J-H, Won S-J, Moon J-H, Kim C-W, Ahn Y-S. Control of Fungal Diseases and Increase in Yields of a Cultivated Jujube Fruit (Zizyphus jujuba Miller var. inermis Rehder) Orchard by Employing Lysobacter antibioticus HS124. Forests. 2019; 10(12):1146. https://doi.org/10.3390/f10121146
Chicago/Turabian StyleKwon, Jun-Hyeok, Sang-Jae Won, Jae-Hyun Moon, Chul-Woo Kim, and Young-Sang Ahn. 2019. "Control of Fungal Diseases and Increase in Yields of a Cultivated Jujube Fruit (Zizyphus jujuba Miller var. inermis Rehder) Orchard by Employing Lysobacter antibioticus HS124" Forests 10, no. 12: 1146. https://doi.org/10.3390/f10121146
APA StyleKwon, J.-H., Won, S.-J., Moon, J.-H., Kim, C.-W., & Ahn, Y.-S. (2019). Control of Fungal Diseases and Increase in Yields of a Cultivated Jujube Fruit (Zizyphus jujuba Miller var. inermis Rehder) Orchard by Employing Lysobacter antibioticus HS124. Forests, 10(12), 1146. https://doi.org/10.3390/f10121146

